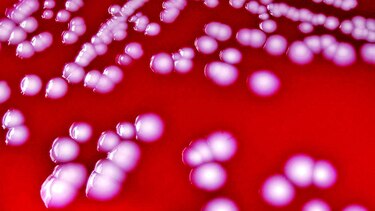
Campaña sobre uso de antibióticos

Através de los años, los antibióticos han sido utilizados de manera indiscriminada.
Las personas se automedican o le exigen a los médicos que les receten antibióticos, aunque no los necesiten; cuando los toman, apenas se sienten mejor, abandonan el tratamiento. Hay además, un uso indiscriminado de antibióticos en la parte agrícola. Todo esto ha ido contribuyendo a que las bacterias se vayan capacitando en mecanismos de defensa hacia esos antibióticos. En otras palabras, que se vuelvan resistentes, explica la doctora Monique Baudrit, gerente médica de la farmacéutica Pfizer para cuidados críticos y hospitalarios.
Añade que esto es un gran riesgo porque se puede llegar a un momento en que las personas tengan una infección por una superbacteria, totalmente resistente a todos los antibióticos existentes.
De hecho, ya hay bacterias llamadas multidrogo-resistentes.
“Se estima que la resistencia bacteriana es causal de aproximadamente 700 mil muertes por año en el mundo y para el año 2050, las bacterias resistentes a los antibióticos podrían matar hasta 10 millones de personas al año”.
Un paciente con una infección bacteriana multidrogo-resistente va a pasar más tiempo en el hospital, se complica, se puede sobreinfectar, no solo con bacterias, sino con hongos, y requerirá cuidados más especializados; todo esto representa también mayores costos para el sistema de salud.
Pfizer ha lanzado una campaña para concienciar a la comunidad científica y al público en general sobre el uso adecuado de los antibióticos.

En términos de la investigación y desarrollo de fármacos, Baudrit añade que hay un compromiso mundial para que las industrias farmacéuticas desarrollen 10 antibióticos en los próximos 20 años. “Es una iniciativa importante para tratar de solucionar un poco la resistencia bacteriana. El primero de esos antibióticos de Pfizer se lanzará en el primer trimestre de 2018 en Panamá”.
Baudrit recomienda el lavado de manos, no automedicarse, usar los medicamentos por el tiempo prescrito, así como la prescripción responsable de los antibióticos.
MEDICAMENTOS INNOVADORES
Recientemente, la Organización Mundial de la Salud (OMS) había alertado sobre la “seria escasez” de nuevos antibióticos en desarrollo para combatir las bacterias cada vez más resistentes, e hizo un llamado para aumentar las inversiones con ese fin.
De acuerdo con información de la agencia AFP, la OMS registró 51 nuevos antibióticos en fase de desarrollo clínico para luchar contra los agentes patógenos prioritaros, así como la tuberculosis y la infección diarreica debida al Clostridium difficile. Pero solo ocho son tratamientos “innovadores” capaces de reforzar el “arsenal” existente.
Además de la tuberculosis resistente, que cada año mata a 250 mil personas en el mundo, la OMS había publicado en febrero una lista de 12 familias de “superbacterias” contra las que considera urgente desarrollar nuevos medicamentos, entre ellas, algunas Acinetobacter y enterobacterias como Klebsiella y E. coli, publicó AFP.
Algunas de estas familias provocan infecciones comunes como la neumonía y las del tracto urinario.